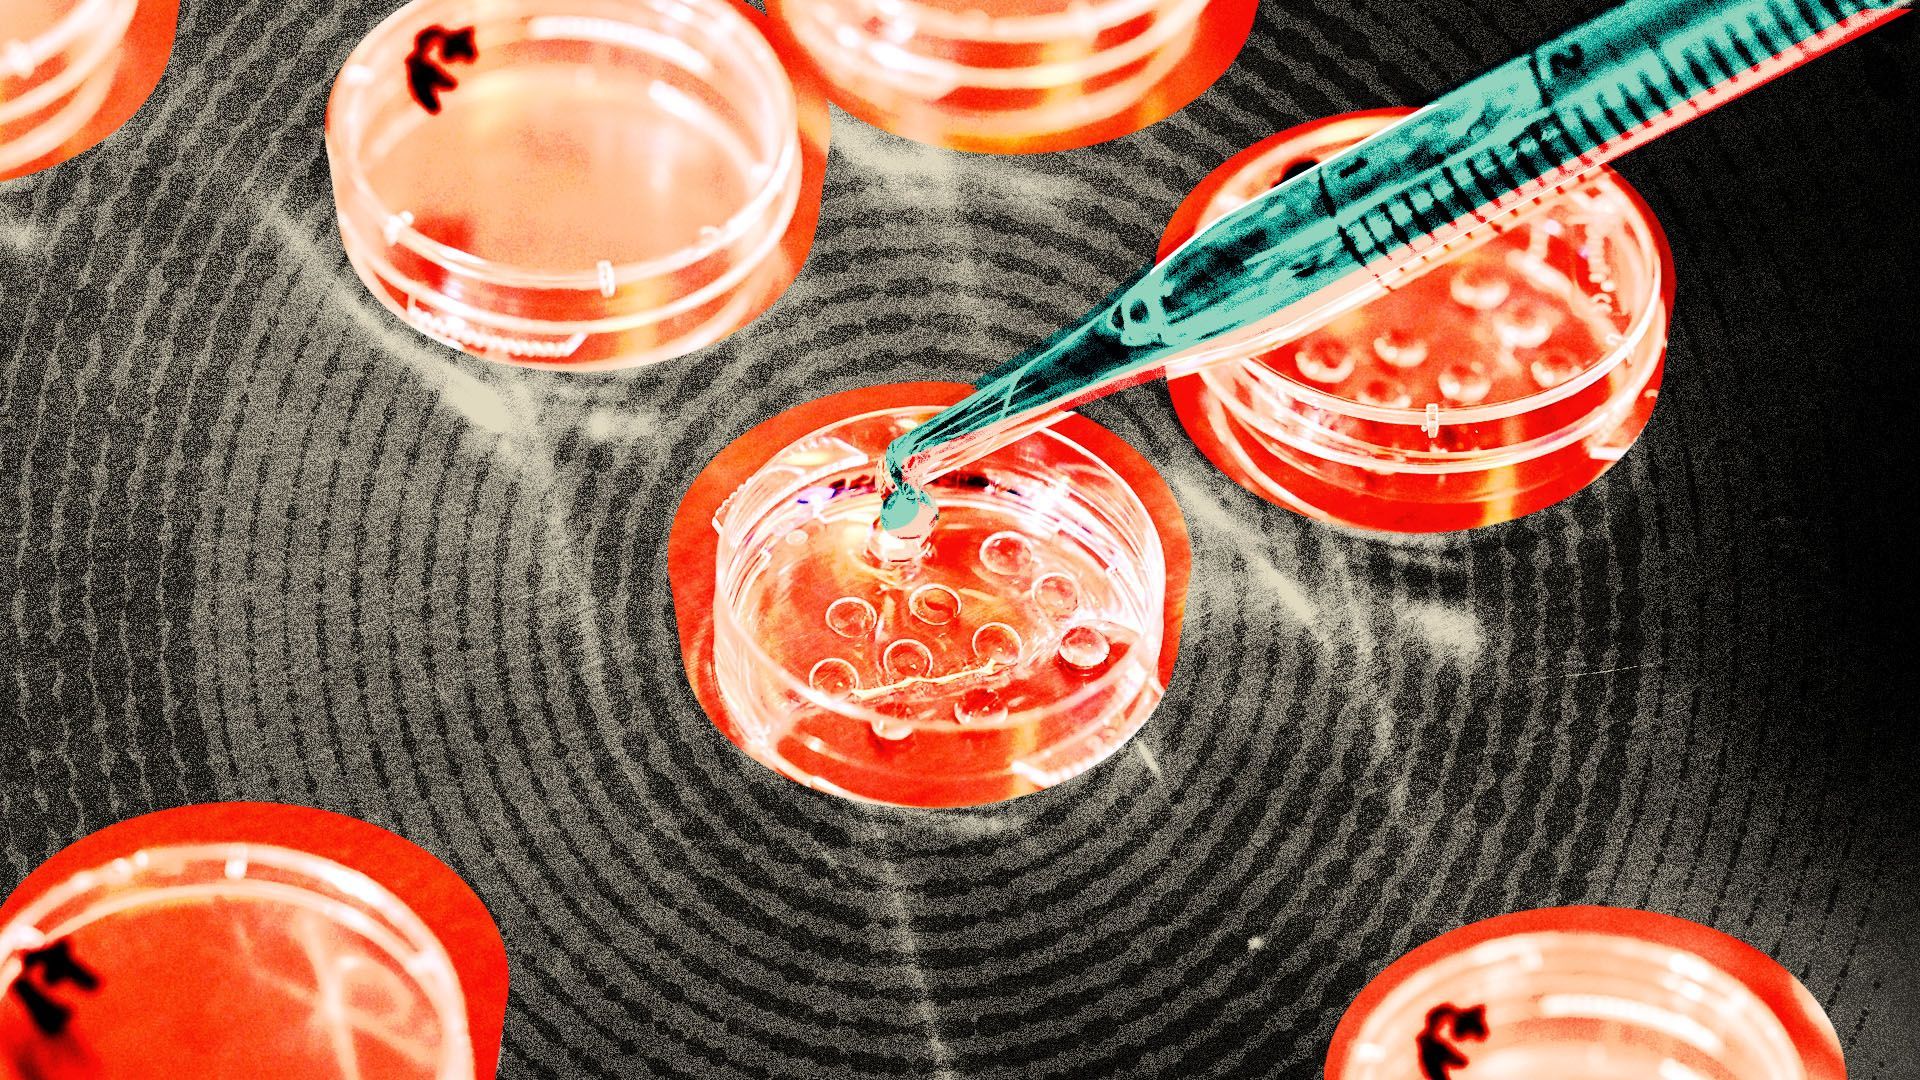
Collage of culture dishes being prepared to collect eggs egg retrieval surrounded by radial lines

Feb 23, 2024 - News
Gov. Lee says he supports IVF
Add Axios as your preferred source to
see more of our stories on Google.

Photo illustration: Sarah Grillo/Axios. Photo: Jens Kalaene/picture alliance via Getty Images
Add Axios as your preferred source to
see more of our stories on Google.
Photo illustration: Sarah Grillo/Axios. Photo: Jens Kalaene/picture alliance via Getty Images